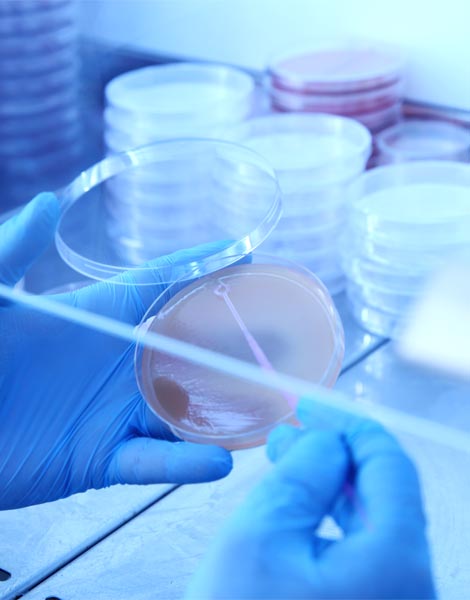
D D 1227

Food Microbiological Analyses
Kazlıçeşme Laboratories carries out microbiology analyses in accordance with and accredited to ISO TS EN 17025 standard, with expert staff and state-of-the-art methods in foods.
Compliance of food samples with food safety legislation is determined by studies carried out with up-to-date international and nationally valid methods, and reported by protecting customer and brand information. Food pathogens, which can be observed in our country as well as all over the world and can cause significant health problems, can be examined with fast and reliable methods.
Service is provided with a solution-oriented approach that provides information to the manufacturer about the detection of microbiological nonconformities that may arise from process processes or the supply chain.